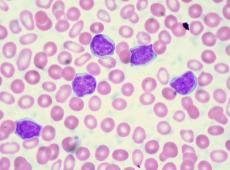

I temi del fine vita al centro del convegno “Nascere e morire tra accettazione e rifiuto”
Organizzato dall'Ordine dei medici di Palermo, guidato da Toti Amato "per accendere i fari su un tema spinoso ed accogliere le riflessioni anche di giuristi e medici siciliani in vista di una possibile rivisitazione della legge di fine vita".